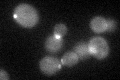
YNL272C
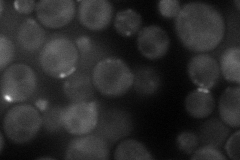
YNL272C
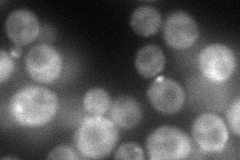
YNL272C
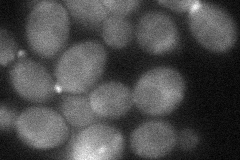
YNL272C
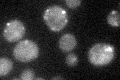
YNL272C

View description
Guanyl-nucleotide exchange factor for the small G-protein Sec4p; essential for post-Golgi vesicle transport; associates with the exocyst, via exocyst subunit Sec15p, on secretory vesicles
Localization:
Intensity:
Fold change:
Significance:
-
C’ GFP library in SD
cytosol:bud neckN/A -
N' NOP1pr-GFP in SD
bud neck64.1193 -
N' TEF2pr-mCherry in SD
bud neck74.7668 -
N' NATIVEpr-GFP in SD

bud neck32.7046 -
N' TEF2pr-VC and Cyto-VN in SD
cytosol,bud neck43.6448 -
C’ GFP library in SD+DTT

cytosol.bud neck28.920.91No -
C’ GFP library in SD+H2O2

cytosolN/AN/ANo -
C’ GFP library in Starvation Media
punctate32.541.03No -
C’ GFP library on the background of Pup2-DaMP

cytosol:bud neck -
C’ GFP library on the background of CCT mutant

cytosol:bud neck23.78360.75465No
